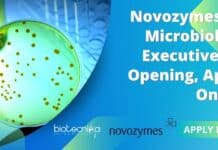
Novozymes QC Microbiology Executive Job Opening, Apply Online Novozymes QC Microbiology Executive

Research Assistant Job For MSc Life Sciences Candidates at MAHE, Manipal
Research Assistant Job For MSc Life Sciences Candidates at MAHE, Manipal
Research Assistant Job For MSc Life Sciences Candidates at MAHE, Manipal. Manipal Academy of...
CSRTI Central Silk Board JRF Job For Biotech, Biochem, Zoology, Mol Bio, Life Sciences
CSRTI Central Silk Board JRF Job For Biotech, Biochem, Zoology, Mol Bio, Life Sciences
CSRTI Central Silk Board JRF Job For Biotech, Biochem, Zoology, Mol...
CMERTI Silk Board BSc & MSc Life Sciences Jobs Available, Attend Walk-In
CMERTI Silk Board BSc & MSc Life Sciences Jobs Available, Attend Walk-In
CMERTI Silk Board BSc & MSc Life Sciences Jobs Available, Attend Walk-In. MSc...
NICED Walk-In-Interview For JRF Post – MSc Life Sciences Candidates Eligible
NICED JRF Vacancy 2023 For MSc Life Sciences, Attend Walk-In
NICED JRF Vacancy 2023 For MSc Life Sciences, Attend Walk-In. MSc Life Sciences JRF job...
Sathyabama Institute of Science and Technology PhD Admissions 2023 July Session
Sathyabama PhD Admissions 2023 July Session
Sathyabama PhD Admissions 2023 July Session. Sathyabama Institute of Science and Technology PhD Admissions 2023 July Session. Interested and...
IBAB SRF Post In Synthetic Biology Group For MSc Life Sciences, Biotech, Biochem, Genetics,...
IBAB SRF Post In Synthetic Biology Group For MSc Life Sciences, Biotech, Biochem, Genetics, Zoology & Mol Bio Candidates
IBAB SRF Post In Synthetic Biology...
Biotecnika Times Newsletter 06.04.2023 Govt HPPSC Jobs, Govt Summer Internship, CSIR NET LIVE Webinar...
Biotecnika Times Newsletter 06.04.2023 Govt HPPSC Jobs, Govt Summer Internship, CSIR NET LIVE Webinar + Podcast
Govt HPPSC Scientific Officer Pollution Control Board Recruitment 2023,...
60 Days To Success in CSIR NET – An Exclusive CSIR NET Podcast By...
The Success Podcast - An Exclusive CSIR NET Podcast By Biotecnika - Episode 1
Welcome to the Success Podcast
An exclusive CSIR NET podcast initiative by...
BSc, MSc & BTech Biotech, Life science Research Assistant Job at Virtis Bio Labs
Virtis Bio Labs Job For BSc, MSc & BTech Biotech, Life Science Candidates
Virtis Bio Labs Job For BSc, MSc & BTech Biotech, Life science...
IQVIA Safety Associate Trainee Job For BSc Life Sciences, Apply Online
IQVIA Safety Associate Trainee Job For BSc Life Sciences, Apply Online
IQVIA Safety Associate Trainee Job For BSc Life Sciences, Apply Online. Interested and eligible...
Pall Corporation Bioprocessing Specialist Job For Biotech Candidates, Apply Via LinkedIn
Pall Corporation Bioprocessing Specialist Job For Biotech Candidates, Apply Via LinkedIn
Pall Corporation Bioprocessing Specialist Job For Biotech Candidates, Apply Via LinkedIn. Pall Corporation biotechnology...
Govt MoEF&CC Summer Internship Scheme 2023 – Applications Invited Online
MoEF&CC Summer Internship Scheme 2023 - Applications Invited Online
MoEF&CC Summer Internship Scheme 2023 - Applications Invited Online. Govt MoEF&CC Summer Internship 2023. Interested applicants...
Novozymes QC Microbiology Executive Job Opening, Apply Online
Novozymes QC Microbiology Executive Job Opening, Apply Online
Novozymes QC Microbiology Executive Job Opening, Apply Online. Microbiology candidates are encouraged to apply for an EXECUTIVE...
NIPER PDF & JRF Jobs For Life Sciences, Biophysics and Biology Candidates
NIPER PDF & JRF Jobs For Life Sciences, Biophysics and Biology Candidates
NIPER PDF & JRF Jobs For Life Sciences, Biophysics and Biology Candidates. NIPER...
CFTRI NON-NET MSc Biochem & Mol Bio Project Job Openings, Apply Online
CFTRI NON-NET MSc Biochem & Mol Bio Project Job Openings, Apply Online
CFTRI NON-NET MSc Biochem & Mol Bio Project Job Openings, Apply Online. CSIR-CFTRI...